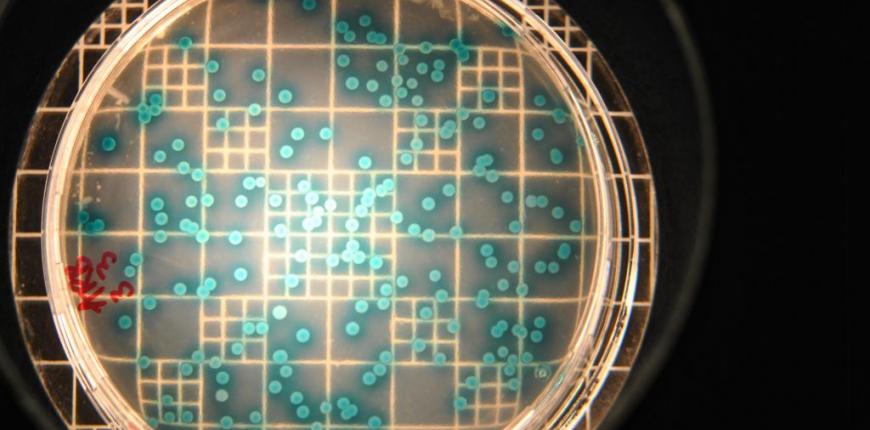
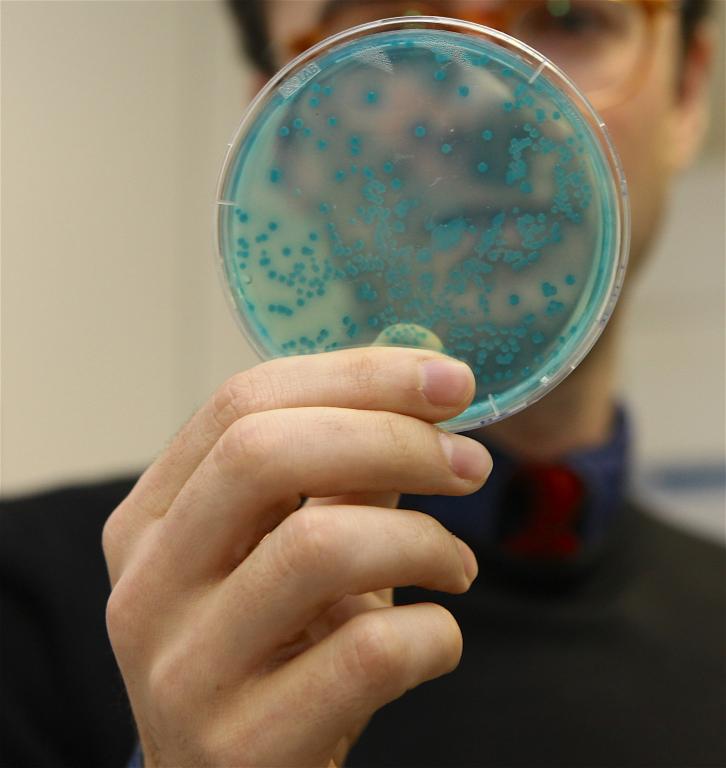

Antibiyotik Direncini Kontrol Altına Almak İçin Yenilikçi Enzim Biyoreaktörleri
Boğaziçi Üniversitesi Çevre Bilimleri Enstitüsü Öğretim Üyesi Yrd. Doç. Dr. Ulaş Tezel, TÜBİTAK desteği ile yürüttüğü çalışma ile günlük hayatımızda sıkça kullandığımız temizlik ve kişisel bakıp ürünlerinin içeriğinde bulunan kimyasalların çevreye salınımını önlemeyi hedefleyen bir proje sürdürüyor.
Yrd. Doç. Dr. Ulaş Tezel, özellikle günlük hayatımızda kullandığımız kişisel bakım ve temizlik ürünlerinin içinde bulunan birtakım kimyasalların dolaylı olarak antibiyotik direncine neden olduğu konusunda uyarıda bulundu. Tezel, “Hepimiz, bizi hasta yapan mikroplardan korkuyoruz. Bu nedenle onlardan kurtulmak, böylece sağlıklı bir yaşam ortamı yaratmak için dezenfektanlar kullanıyoruz. Bizim bu hijyen takıntımız mikroplara dezenfektanlarla baş etmeyi öğretti. Gelişi güzel dezenfektan kullanımımız nedeniyle mikropların geliştirdiği bu yetiye bilim literatüründe “antimikrobiyal direnci” denmektedir. Birçok antimikrobiyal direnç mekanizması antibiyotiklere karşı da etkin olduğu için günümüzde bu durum insan sağlığı için önemli bir tehdit oluşturmaktadır” dedi.
Temizlik için kullanılan dezenfektanların aktif maddeleri olan biyositlerin atıksuya karıştığını belirten Tezel, özellikle dünyada bu ürünlerin kullanımının yaygınlaşması ile birlikte doğaya salınımın çok arttığını belirtti. Tezel’in verdiği bilgiye göre doğaya karışan bu biyositler mikroplarla buluşarak bir anlamda doğa içinde aşı görevi de görmeye bayılıyor ve mikropların, geliştirilen antibiyotiklere karşı direncinin artmasına neden oluyor.
Tezel bu konuda şu açıklamayı yaptı: “Organik maddeler ve biyositler gibi mikrokirleticiler içeren atıksu arıtılıp, alıcı ortamlara deşarj edilir. Birçok atıksu arıtma tesisi, kolaylıkla parçalanabilir organik kirleticilerin arıtımı için tasarlanmıştır. Bu nedenle, biyositler dahil olmak üzere antibiyotikler, ağrı kesiciler, östrojenik kimyasallar gibi birçok mikrokirletici, atık su arıtma tesislerinden arıtılmadan geçerek çevreye salınır. Antimikrobiyal direnç gelişiminin ana nedeninin mikroorganizmaların antimikrobiyal kimyasallara (biyositler ve antibiyotikler) çevrede düşük konsantrasyonlarda maruz kalması olduğu düşünülürse, bu kimyasalların çevredeki varlığı önemli bir problem teşkil etmektedir. Antimikrobiyal direnci insan toplumunun bugün karşı karşıya olduğu en önemli sağlık problemidir.”
Çevrede antimikrobiyal direncinin gelişmesi ve yayılması riskini azaltmak için gereken stratejinin, çevreye antimikrobiyal kimyasalların salınımını kontrol etmek olduğunu belirten Tezel, şu bilgileri verdi: “Biyoparçalama/biyodönüşüm, atıksu arıtımı sırasında bu kimyasalların çevreye salınmadan bertarafını sağlayabilecek en etkin mekanizmadır. Ancak konvansiyonel biyolojik atıksu arıtma tesisleri, birçok mikrokirleticinin arıtımında yetersiz kalmaktadır. Bu kirleticilerin çevreye salınımını önlemek için ileri arıtma teknolojilerinin geliştirilmesi şarttır. Benzalkonyum klorürler (BAK), evsel, endüstriyel ve hastane atıksularında diğer mikrokirleticilere göre daha yüksek konsantrasyonlarda bulunan bir grup antimikrobiyal kimyasaldır. Bu kimyasalın özellikle hastalık yapıcı mikroorganizmalarda antimikrobiyal direncini tetiklediği ve bu mikroorganizmaların birçok antibiyotiğe toleranslı hale geldiği literatürde belirtilmiştir. Laboratuvarımızda TÜBİTAK projemiz kapsamında biyolojik arıtımdan geçmiş atık sulardan BAK ve benzeri antimikrobiyal kirleticilerin temizlenmesi için yüksek verimli bir ileri arıtma teknolojisi geliştirmekteyiz. Şuana kadar biyolojik olarak parçalanması çok zor olan kirleticileri parçalayan Pseudomonas cinsi bir bakteri keşfettik. Bu bakterinin genom dizilimini elde edip bu kirleticileri parçalamasını sağlayan genleri belirledik. Bu bakteriyi doğal bir materyale hapsedip bir biyokatalizör hazırladık ve bu biyokatalizör ile doldurulmuş reaktörlerde atıksudan %100 oranında BAK arıtımı sağladık. İleriki aylarda bakterimizden elde ettiğimiz BAK parçalayan BAK-oksijenaz enzimiyle hazırlanan biyokatalizör yardımıyla yarım saat gibi düşük sıvı bekletme sürelerinde atıksulardan %100 verimle BAK giderimi elde etmeyi planlıyoruz”.
Tezel şöyle devam etti: ‘’Enzim biyoreaktörleri ilaç ve besin sanayinde oldukça sık kullanılmaktadır. Bu tip reaktörlerin atık su arıtımına yönelik uygulamaları oldukça azdır. Bu nedenle, bu projenin çıktıları alanında bir ilk olmakla kalmayıp, ileri atıksu arıtımına yenilikçi bir teknoloji kazandıracaktır. Bu proje kapsamında elde edilecek enzimler ile hazırlanacak katalizörler sadece evsel atıksuların değil ayrıca ilaç endüstrisi ve hastane atıksuları gibi içerisinde birçok antimikrobiyal kimyasal bulunan atıksuların arıtımı için de kullanılabilir. Bu nedenle bu projenin sonuçları gerek çevre gerekse insan sağlığının korunmasına önemli katkılarda bulunacaktır’’.